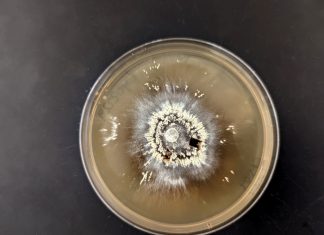
UC Riverside research: Meet the forest microbes that can survive megafires UC Riverside research: Meet the forest microbes that can survive megafires

Depression increases stroke risk in mid-age women
Worldwide, stroke is the second leading cause of death, responsible for 4.4 million (9 percent) of the total 50.5 million deaths each year. Stroke...
UC Riverside research: Meet the forest microbes that can survive megafires
New UC Riverside research shows fungi and bacteria able to survive redwood tanoak forest megafires are microbial “cousins” that often increase in abundance after...
Pre-pregnancy diabetes poses a triple risk for MRSA
Methicillin-resistant Staphylococcus aureus (MRSA) infection is caused by a strain of staph bacteria that's become resistant to the antibiotics commonly used to treat ordinary...
Study: Fungal meningitis spreads by blocking and bursting blood vessels
New research from the University of Sheffield has revealed how fungus blocks and bursts blood vessels in the brain, helping scientists better understand how...
Prenatal depression may cause mood and anxiety disorders in infants
Children of depressed parents are at an increased risk of developing depression themselves, a combination of both genetic and environmental factors. However, because offspring...
Scientists take important step towards development of biological dental enamel
To this day, cavities and damage to enamel are repaired by dentists with the help of synthetic white filling materials. There is no natural...
Inconsistent sleep and sleep duration linked to excess weight
Past cross-sectional studies have found a link between short sleep duration and obesity. One of the largest and longest studies on adult sleep habits...
Study: Novel treatment effective for sidewall brain aneurysm
A novel mesh plug that has been traditionally used to treat brain aneurysms occurring where the blood vessels branch out was found to be...
Environmental Chemicals Harm Reproductive Health
Toxic chemicals in the environment harm our ability to reproduce, negatively affect pregnancies, and are associated with numerous other long-term health problems, according to...
New research: Genetics affects functions of gut microbiome
New research from Cornell scientists is exploring how human genetics impacts functions of the gut microbiome, and is expanding awareness of the role human...